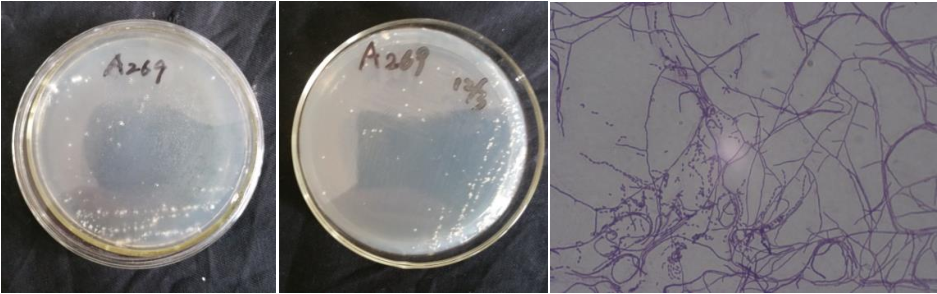

Loading...
| StrainNO | A269 |
| Classification | Actinomadura |
| 16s rDNA sequence | CTGCCCTTGGCTCTGGGATAAGCCCGGGAAACTGGGTCTAATACCGGATATGACCATCTCACGCATGTGATGGTGGTGGAAAGT TTTTCGGCTGGGGATGGGCTCGCGGCCTATCAGCTTGTTGGTGGGGTAGTGGCCTACCAAGGCGACGACGGGTAGCCGGCCTGA GAGGGCGACCGGCCACACTGGGACTGAGACACGGCCCAGACTCCTACGGGAGGCAGCAGTGGGGAATATTGCACAATGGGCGGA AGCCTGATGCAGCGACGCCGCGTGGGGGATGAAGGCCTTCGGGTTGTAAACCTCTTTCAGCACCGACGAAGGTGACGGTAGGTG CAGAAGAAGCGCCGGCTAACTACGTGCCAGCAGCCGCGGTAATACGTAGGGCGCAAGCGTTGTCCGGAATTATTGGGCGTAAAG AGCTCGTAGGCGGTTTGTCGCGTCTGTCGTGAAAGCTCGCAGCTTAACTGCGGGTCTGCGGTGGATACGGGCAGGCTAGAGGCA GGTAGGGGAGAACGGAATTCCCGGTGTAGCGGTGAAATGCGCAGATATCGGGAGGAACACCGGTGGCGAAGGCGGTTCTCTGGG CCTGTACTGACGCTGAGGAGCGAAAGCGTGGGGAGCGAACAGGATTAGATACCCTGGTAGTCCACGCCGTAAACGTTGGGCGCT AGGTGTGGGGTTCTTCCACGGATTCCGCGCCGTAGCTAACGCATTAAGCGCCCCGCCTGGGGAGTACGGCCGCAAGGCTAAAAC TCAAAGGAATTGACGGGGGCCCGCACAAGCGGCGGAGCATGTTGCTTAATTCGACGCAACGCGAAGAACCTTACCAAGGCTTGA CATCACCCGAAAACCGGCGGAGACGTCGGGTCCTTTTGGGCGGGTGACAGGTGGTGCATGGCTGTCGTCAGCTCGTGTCGTGAG ATGTTGGGTTAAGTCCCGCAACGAGCGCAACCCTCGTTCCATGTTGCCAGCACGTTATGGTGGGGACTCATGGGAGACTGCCGG GGTCAACTCGGAGGAAGGTGGGGATGACGTCAAGTCATCATGCCCCTTATGTCTTGGGCTGCAAACATGCTACAATGGCCGGTA CAGAGGGCTGCGATACCGCGAGGTGGAGCGAATCCCTAAAAGCCGGTCTCAGTTCGGATTGGGGTCTGCAACTCGACCCCATGAAGTCGGAGTCGCTAGTAATCGCAGATCAGCAACGCTGCGGTGAATACGTTCCCGGGCCTTGTACACACCGCCCGTCACGTCACG AAAGTCGGCAACACCCGAAGCCCGTGGCCCAACCCGTGAGGGGGGGAGCGGTCGAAGGTGGGGCCGGCGATTGGGACGAAGTCG TAACAAGGTA |
| Strain Morphology Photos | |
| Morphological Description | hyphae:branched;separated without breaking;spore filaments:bent and broken into Rod-shaped bodies;spore pile:pink white;back:fried beige |